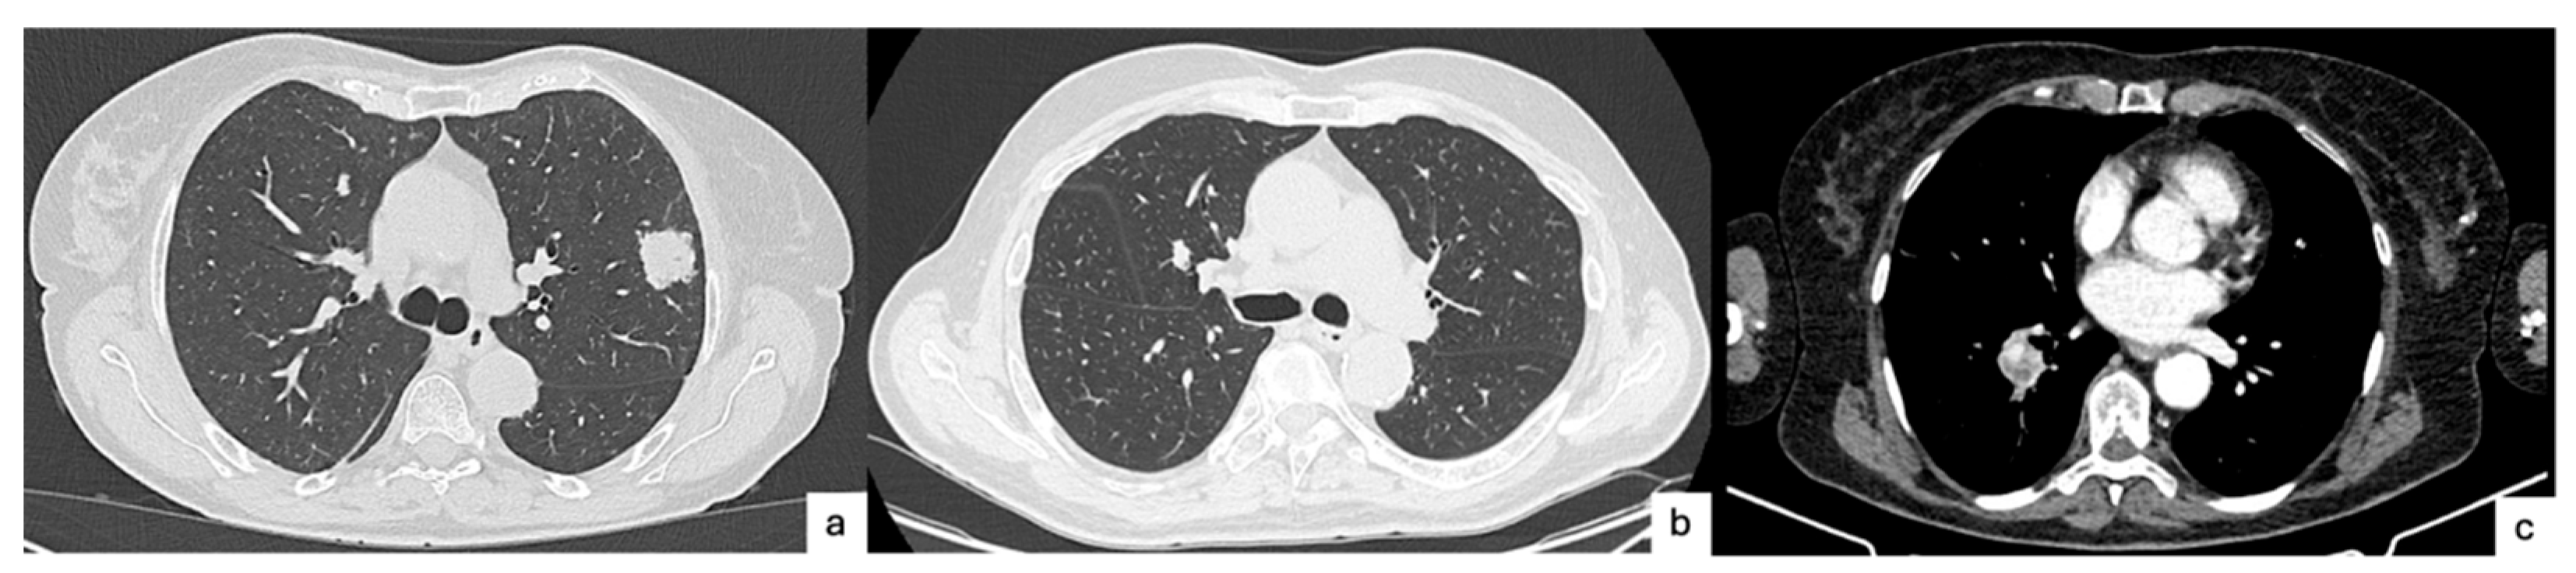
Cancers 17 03374 g001 Cancers 17 03374 g001

Multidisciplinary Perspective of Spread Through Air Spaces in Lung Cancer: A Narrative Review
Simple Summary
Abstract
1. Introduction
2. Pathogenesis
3. Radiologic Perspective
4. Pathologic Perspective
- Micropapillary clusters—papillary structures without a central fibrovascular core, sometimes forming ring-like shapes within alveolar spaces.
- Solid nests or tumor islands—compact groups of tumor cells occupying alveolar spaces.
- Single tumor cells—scattered, free-floating cancer cells within the alveoli.
5. Surgical Perspective
6. Chemotherapeutic Perspective
7. Radiotherapeutic Perspective
8. Future Directions
- Clarifying the biological mechanism: the underlying biology of STAS remains largely speculative. Future studies should focus on unraveling the molecular and cellular pathways that enable tumor cells to detach, survive, and migrate through alveolar spaces. Particular attention should be given to EMT, tumor–stroma interactions, and immune evasion mechanisms, including the role of tumor-associated macrophages and PD-L1 expression.
- Standardizing diagnostic criteria: variability in the pathological identification of STAS—compounded by interobserver differences and the potential for surgical artifacts—calls for standardized diagnostic protocols. Consensus guidelines should be developed to distinguish true STAS from artifacts, potentially incorporating 3D histology, immunohistochemistry, and AI-assisted digital pathology.
- Enhancing preoperative detection: frozen section analysis currently lacks the sensitivity needed for reliable intraoperative decision-making. Future work should refine imaging-based predictive tools, including CT feature analysis, PET/CT metabolic profiling, and advanced radiomic models. Integrating machine learning and deep learning algorithms may further improve accuracy, enabling personalized surgical planning before tumor resection.
- Integrating STAS into clinical staging and risk stratification: STAS is a strong prognostic factor but is not yet formally integrated into lung cancer staging systems. Risk models that include STAS, tumor size, margin distance, and molecular profiles could guide more nuanced treatment algorithms.
- Personalizing surgical strategies: emerging evidence suggests that lobectomy offers better outcomes than sublobar resection for STAS-positive patients, even in early-stage disease. Future clinical trials should assess whether segmentectomy, wedge resection, or more extensive surgery is optimal for specific STAS subtypes or locations (e.g., bronchiolar vs. alveolar STAS). The margin-to-tumor ratio should also be further validated as a surgical planning tool.
- Evaluating the role of adjuvant therapy: adjuvant chemotherapy appears beneficial in STAS-positive stage I patients, particularly after limited resection. However, optimal treatment regimens, timing, and patient selection criteria remain undefined. Prospective, STAS-stratified trials are needed to clarify the role of chemotherapy and radiotherapy across histologic subtypes and resection strategies.
9. Conclusions
Author Contributions
Funding
Conflicts of Interest
Abbreviations
| AC | Atypical carcinoid |
| AUC | Area under the curve |
| CT | Computed tomography |
| DFS | Disease-free survival |
| EMT | Epithelial–mesenchymal transition |
| FDG | Fluorodeoxyglucose |
| GGO | Ground-glass opacity |
| LCNEC | Large cell neuroendocrine carcinomas |
| MMP-7 | Matrix metalloproteinase-7 |
| NET | Neuroendocrine tumors |
| NSCLC | Non-small cell lung cancer |
| OS | Overall survival |
| PD-L1 | Programmed death-ligand 1 |
| PET | Positron emission tomography |
| SBRT | Stereotactic body radiotherapy |
| SCLC | Small-cell lung cancer |
| SMA | Smooth muscle actin |
| STAKS | Spread through a knife surface |
| STAS | Spread through air spaces |
| SUV | Standardized uptake value |
| TAMs | Tumor-associated macrophages |
| TC | Typical carcinoid |
References
- Sung, H.; Ferlay, J.; Siegel, R.L.; Laversanne, M.; Soerjomataram, I.; Jemal, A.; Bray, F. Global Cancer Statistics 2020: GLOBOCAN Estimates of Incidence and Mortality Worldwide for 36 Cancers in 185 Countries. CA Cancer J. Clin. 2021, 71, 209–249. [Google Scholar] [CrossRef]
- Kadota, K.; Nitadori, J.; Sima, C.S.; Ujiie, H.; Rizk, N.P.; Jones, D.R.; Adusumilli, P.S.; Travis, W.D. Tumor Spread through Air Spaces is an Important Pattern of Invasion and Impacts the Frequency and Location of Recurrences after Limited Resection for Small Stage I Lung Adenocarcinomas. J. Thorac. Oncol. 2015, 10, 806–814. [Google Scholar] [CrossRef]
- Travis, W.D.; Brambilla, E.; Nicholson, A.G.; Yatabe, Y.; Austin, J.H.M.; Beasley, M.B.; Chirieac, L.R.; Dacic, S.; Duhig, E.; Flieder, D.B.; et al. The 2015 World Health Organization Classification of Lung Tumors: Impact of Genetic, Clinical and Radiologic Advances Since the 2004 Classification. J. Thorac. Oncol. 2015, 10, 1243–1260. [Google Scholar] [CrossRef]
- Li, J.; Wang, Y.; Li, J.; Cao, S.; Che, G. Meta-analysis of Lobectomy and Sublobar Resection for Stage I Non-small Cell Lung Cancer With Spread Through Air Spaces. Clin. Lung Cancer 2022, 23, 208–213. [Google Scholar] [CrossRef] [PubMed]
- Gross, D.J.; Hsieh, M.-S.; Li, Y.; Dux, J.; Rekhtman, N.; Jones, D.R.; Travis, W.D.; Adusumilli, P.S. Spread Through Air Spaces (STAS) in Non−Small Cell Lung Carcinoma. Am. J. Surg. Pathol. 2021, 45, 1509–1515. [Google Scholar] [CrossRef]
- Xia, T.; Yuan, Q.; Xing, S.-G. STAS: New explorations and challenges for thoracic surgeons. Clin. Transl. Oncol. 2024, 27, 1345–1355. [Google Scholar] [CrossRef] [PubMed]
- Lamouille, S.; Xu, J.; Derynck, R. Molecular mechanisms of epithelial–mesenchymal transition. Nat. Rev. Mol. Cell Biol. 2014, 15, 178–196. [Google Scholar] [CrossRef]
- Jia, M.; Yu, S.; Yu, J.; Li, Y.; Gao, H.; Sun, P.-L. Comprehensive analysis of spread through air spaces in lung adenocarcinoma and squamous cell carcinoma using the 8th edition AJCC/UICC staging system. BMC Cancer 2020, 20, 705. [Google Scholar] [CrossRef] [PubMed]
- Ikeda, T.; Kadota, K.; Yoshida, C.; Ishikawa, R.; Go, T.; Haba, R.; Yokomise, H. The epithelial-mesenchymal transition phenotype is associated with the frequency of tumor spread through air spaces (STAS) and a High risk of recurrence after resection of lung carcinoma. Lung Cancer 2021, 153, 49–55. [Google Scholar] [CrossRef]
- Yamada, K.; Kadota, K.; Fujimoto, S.; Yoshida, C.; Ibuki, E.; Ishikawa, R.; Haba, R.; Yokomise, H.; Yajima, T. MMP-7 expression is associated with a higher rate of tumor spread through air spaces in resected lung adenocarcinomas. Lung Cancer 2022, 175, 125–130. [Google Scholar] [CrossRef]
- Qiu, X.; Chen, D.; Liu, Y.; Duan, S.; Zhang, F.; Zhang, Y.; Li, F.; Chen, C.; Chen, Y. Relationship between stromal cells and tumor spread through air spaces in lung adenocarcinoma. Thorac. Cancer 2019, 10, 256–267. [Google Scholar] [CrossRef] [PubMed]
- Yoshida, C.; Kadota, K.; Ikeda, T.; Ibuki, E.; Go, T.; Haba, R.; Yokomise, H. Tumor-associated macrophage infiltration is associated with a higher rate of tumor spread through air spaces in resected lung adenocarcinomas. Lung Cancer 2021, 158, 91–96. [Google Scholar] [CrossRef] [PubMed]
- Wang, S.; Shou, H.; Wen, H.; Wang, X.; Wang, H.; Lu, C.; Gu, J.; Xu, F.; Zhu, Q.; Wang, L.; et al. An individual nomogram can reliably predict tumor spread through air spaces in non-small-cell lung cancer. BMC Pulm. Med. 2022, 22, 209. [Google Scholar] [CrossRef] [PubMed]
- Lee, J.S.; Kim, E.K.; Kim, M.; Shim, H.S. Genetic and clinicopathologic characteristics of lung adenocarcinoma with tumor spread through air spaces. Lung Cancer 2018, 123, 121–126. [Google Scholar] [CrossRef]
- Laville, D.; Désage, A.L.; Fournel, P.; Bayle-Bleuez, S.; Neifer, C.; Picot, T.; Sulaiman, A.; Tiffet, O.; Forest, F. Spread Through Air Spaces in Stage I to III Resected Lung Adenocarcinomas: Should the Presence of Spread Through Air Spaces Lead to an Upstaging? Am. J. Surg. Pathol. 2024, 48, 596–604. [Google Scholar] [CrossRef]
- Blaauwgeers, H.; Flieder, D.; Warth, A.; Harms, A.; Monkhorst, K.; Witte, B.; Thunnissen, E. A Prospective Study of Loose Tissue Fragments in Non-Small Cell Lung Cancer Resection Specimens: An Alternative View to “Spread Through Air Spaces”. Am. J. Surg. Pathol. 2017, 41, 1226–1230. [Google Scholar] [CrossRef]
- Metovic, J.; Falco, E.C.; Vissio, E.; Santoro, F.; Delsedime, L.; Massa, F.; Pittaro, A.; Osella-Abate, S.; Cassoni, P.; Volante, M.; et al. Gross Specimen Handling Procedures Do Not Impact the Occurrence of Spread Through Air Spaces (STAS) in Lung Cancer. Am. J. Surg. Pathol. 2020, 45, 215–222. [Google Scholar] [CrossRef]
- Walts, A.E.; Marchevsky, A.M. Current Evidence Does Not Warrant Frozen Section Evaluation for the Presence of Tumor Spread Through Alveolar Spaces. Arch. Pathol. Lab. Med. 2017, 142, 59–63. [Google Scholar] [CrossRef]
- Willner, J.; Narula, N.; Moreira, A.L. Updates on lung adenocarcinoma: Invasive size, grading and STAS. Histopathology 2023, 84, 6–17. [Google Scholar] [CrossRef]
- Toyokawa, G.; Yamada, Y.; Tagawa, T.; Kamitani, T.; Yamasaki, Y.; Shimokawa, M.; Oda, Y.; Maehara, Y. Computed tomography features of resected lung adenocarcinomas with spread through air spaces. J. Thorac. Cardiovasc. Surg. 2018, 156, 1670–1676.e4. [Google Scholar] [CrossRef]
- Kim, S.K.; Chung, M.J.; Kim, T.S.; Lee, K.S.; Zo, J.I.; Shim, Y.M. Lung Adenocarcinoma: CT Features Associated with Spread through Air Spaces. Radiology 2018, 289, 831–840. [Google Scholar] [CrossRef] [PubMed]
- Kameda, F.; Kunihiro, Y.; Tanabe, M.; Nakashima, M.; Kobayashi, T.; Tanaka, T.; Hoshii, Y.; Ito, K. Qualitative and Quantitative Computed Tomography Analyses of Lung Adenocarcinoma for Predicting Spread Through Air Spaces. Tomography 2025, 11, 76. [Google Scholar] [CrossRef]
- Qin, L.; Sun, Y.; Zhu, R.; Hu, B.; Wu, J. Clinicopathological and CT features of tumor spread through air space in invasive lung adenocarcinoma. Front. Oncol. 2022, 12, 959113. [Google Scholar] [CrossRef] [PubMed]
- Zhang, Z.; Liu, Z.; Feng, H.; Xiao, F.; Shao, W.; Liang, C.; Sun, H.; Gu, X.; Liu, D. Predictive value of radiological features on spread through air space in stage cIA lung adenocarcinoma. J. Thorac. Dis. 2020, 12, 6494–6504. [Google Scholar] [CrossRef]
- Nishimori, M.; Iwasa, H.; Miyatake, K.; Nitta, N.; Nakaji, K.; Matsumoto, T.; Yamanishi, T.; Yoshimatsu, R.; Iguchi, M.; Tamura, M.; et al. 18F FDG-PET/CT analysis of spread through air spaces (STAS) in clinical stage I lung adenocarcinoma. Ann. Nucl. Med. 2022, 36, 897–903. [Google Scholar] [CrossRef] [PubMed]
- Chen, D.; She, Y.; Wang, T.; Xie, H.; Li, J.; Jiang, G.; Chen, Y.; Zhang, L.; Xie, D.; Chen, C. Radiomics-based prediction for tumour spread through air spaces in stage I lung adenocarcinoma using machine learning. Eur. J. Cardio-Thoracic Surg. 2020, 58, 51–58. [Google Scholar] [CrossRef]
- Jiang, C.; Luo, Y.; Yuan, J.; You, S.; Chen, Z.; Wu, M.; Wang, G.; Gong, J. CT-based radiomics and machine learning to predict spread through air space in lung adenocarcinoma. Eur. Radiol. 2020, 30, 4050–4057. [Google Scholar] [CrossRef]
- Takehana, K.; Sakamoto, R.; Fujimoto, K.; Matsuo, Y.; Nakajima, N.; Yoshizawa, A.; Menju, T.; Nakamura, M.; Yamada, R.; Mizowaki, T.; et al. Peritumoral radiomics features on preoperative thin-slice CT images can predict the spread through air spaces of lung adenocarcinoma. Sci. Rep. 2022, 12, 10323. [Google Scholar] [CrossRef]
- Liao, G.; Huang, L.; Wu, S.; Zhang, P.; Xie, D.; Yao, L.; Zhang, Z.; Yao, S.; Shanshan, L.; Wang, S.; et al. Preoperative CT-based peritumoral and tumoral radiomic features prediction for tumor spread through air spaces in clinical stage I lung adenocarcinoma. Lung Cancer 2022, 163, 87–95. [Google Scholar] [CrossRef]
- Wang, Y.; Lyu, D.; Hu, L.; Wu, J.; Duan, S.; Zhou, T.; Tu, W.; Xiao, Y.; Fan, L.; Liu, S. CT-Based Intratumoral and Peritumoral Radiomics Nomograms for the Preoperative Prediction of Spread Through Air Spaces in Clinical Stage IA Non-small Cell Lung Cancer. J. Imaging Inform. Med. 2024, 37, 520–535. [Google Scholar] [CrossRef]
- Lin, M.-W.; Chen, L.-W.; Yang, S.-M.; Hsieh, M.-S.; Ou, D.-X.; Lee, Y.-H.; Chen, J.-S.; Chang, Y.-C.; Chen, C.-M. CT-Based Deep-Learning Model for Spread-Through-Air-Spaces Prediction in Ground Glass-Predominant Lung Adenocarcinoma. Ann. Surg. Oncol. 2023, 31, 1536–1545. [Google Scholar] [CrossRef]
- Wang, Y.; Lyu, D.; Cheng, C.; Zhou, T.; Tu, W.; Xiao, Y.; Zuo, C.; Fan, L.; Liu, S. Preoperative nomogram for predicting spread through air spaces in clinical-stage IA non-small cell lung cancer using 18F-fluorodeoxyglucose positron emission tomography/computed tomography. J. Cancer Res. Clin. Oncol. 2024, 150, 185. [Google Scholar] [CrossRef]
- Gao, Z.; An, P.; Li, R.; Wu, F.; Sun, Y.; Wu, J.; Yang, G.; Wang, Z. Development and validation of a clinic-radiological model to predict tumor spread through air spaces in stage I lung adenocarcinoma. Cancer Imaging 2024, 24, 25. [Google Scholar] [CrossRef]
- Song, H.; Cui, S.; Zhang, L.; Lou, H.; Yang, K.; Yu, H.; Lin, J. Preliminary exploration of the correlation between spectral computed tomography quantitative parameters and spread through air spaces in lung adenocarcinoma. Quant. Imaging Med. Surg. 2024, 14, 386–396. [Google Scholar] [CrossRef]
- Giraud, P.; Antoine, M.; Larrouy, A.; Milleron, B.; Callard, P.; De Rycke, Y.; Carette, M.-F.; Rosenwald, J.-C.; Cosset, J.-M.; Housset, M.; et al. Evaluation of microscopic tumor extension in non–small-cell lung cancer for three-dimensional conformal radiotherapy planning. Int. J. Radiat. Oncol. 2000, 48, 1015–1024. [Google Scholar] [CrossRef]
- Amin, M.B.; Tamboli, P.; Merchant, S.H.; Ordóñez, N.G.; Ro, J.; Ayala, A.G.; Ro, J.Y. Micropapillary component in lung adenocarcinoma: A distinctive histologic feature with possible prognostic significance. Am. J. Surg. Pathol. 2002, 26, 358–364. [Google Scholar] [CrossRef] [PubMed]
- Onozato, M.L.; Kovach, A.E.; Yeap, B.Y.S.; Morales-Oyarvide, V.; Klepeis, V.E.; Tammireddy, S.M.; Heist, R.S.; Mark, E.J.; Dias-Santagata, D.; Iafrate, A.J.; et al. Tumor Islands in Resected Early-stage Lung Adenocarcinomas are Associated With Unique Clinicopathologic and Molecular Characteristics and Worse Prognosis. Am. J. Surg. Pathol. 2013, 37, 287–294. [Google Scholar] [CrossRef] [PubMed]
- Travis, W.D.; Eisele, M.; Nishimura, K.K.; Aly, R.G.; Bertoglio, P.; Chou, T.-Y.; Detterbeck, F.C.; Donnington, J.; Fang, W.; Joubert, P.; et al. The International Association for the Study of Lung Cancer (IASLC) Staging Project for Lung Cancer: Recommendation to Introduce Spread Through Air Spaces as a Histologic Descriptor in the Ninth Edition of the TNM Classification of Lung Cancer. Analysis of 4061 Pathologic Stage I NSCLC. J. Thorac. Oncol. 2024, 19, 1028–1051. [Google Scholar] [CrossRef] [PubMed]
- Warth, A.; Muley, T.; Kossakowski, C.A.; Goeppert, B.; Schirmacher, P.; Dienemann, H.; Weichert, W. Prognostic Impact of Intra-alveolar Tumor Spread in Pulmonary Adenocarcinoma. Am. J. Surg. Pathol. 2015, 39, 793–801. [Google Scholar] [CrossRef]
- Uruga, H.; Fujii, T.; Fujimori, S.; Kohno, T.; Kishi, K. Semiquantitative Assessment of Tumor Spread through Air Spaces (STAS) in Early-Stage Lung Adenocarcinomas. J. Thorac. Oncol. 2017, 12, 1046–1051. [Google Scholar] [CrossRef]
- Zhou, F.; Villalba, J.A.; Sayo, T.M.S.; Narula, N.; Pass, H.; Mino-Kenudson, M.; Moreira, A.L. Assessment of the feasibility of frozen sections for the detection of spread through air spaces (STAS) in pulmonary adenocarcinoma. Mod. Pathol. 2021, 35, 210–217. [Google Scholar] [CrossRef] [PubMed]
- Brown, L.M.; Louie, B.E.; Jackson, N.; Farivar, A.S.; Aye, R.W.; Vallières, E. Recurrence and Survival After Segmentectomy in Patients With Prior Lung Resection for Early-Stage Non-Small Cell Lung Cancer. Ann. Thorac. Surg. 2016, 102, 1110–1118. [Google Scholar] [CrossRef]
- Villalba, J.A.; Shih, A.R.; Sayo, T.M.S.; Kunitoki, K.; Hung, Y.P.; Ly, A.; Kem, M.; Hariri, L.P.; Muniappan, A.; Gaissert, H.A.; et al. Accuracy and Reproducibility of Intraoperative Assessment on Tumor Spread Through Air Spaces in Stage 1 Lung Adenocarcinomas. J. Thorac. Oncol. 2020, 16, 619–629. [Google Scholar] [CrossRef]
- Lee, G.Y.; Chung, J.-H.; Cho, S.; Han, Y.B.; Park, Y.M.; Kim, H.-J.; Song, M.J.; Kwon, B.S.; Lim, S.Y.; Lee, Y.J.; et al. Impact of Preoperative Diagnostic Biopsy Procedure on Spread Through Airspaces and Related Outcomes in Resected Stage I Non-Small Cell Lung Cancer. Chest 2022, 162, 1199–1212. [Google Scholar] [CrossRef]
- Chae, M.; Jeon, J.H.; Chung, J.-H.; Lee, S.Y.; Hwang, W.J.; Jung, W.; Hwang, Y.; Cho, S.; Kim, K.; Jheon, S. Prognostic significance of tumor spread through air spaces in patients with stage IA part-solid lung adenocarcinoma after sublobar resection. Lung Cancer 2021, 152, 21–26. [Google Scholar] [CrossRef]
- Chen, S.; Ye, T.; Yang, S.; Zhao, Y.; Zhang, Y.; Huang, Q.; Wu, H.; Hu, H.; Sun, Y.; Zhang, Y.; et al. Prognostic implication of tumor spread through air spaces in patients with pathologic N0 lung adenocarcinoma. Lung Cancer 2022, 164, 33–38. [Google Scholar] [CrossRef]
- Shimomura, M.; Miyagawa-Hayashino, A.; Omatsu, I.; Asai, Y.; Ishihara, S.; Okada, S.; Konishi, E.; Teramukai, S.; Inoue, M. Spread through air spaces is a powerful prognostic predictor in patients with completely resected pathological stage I lung adenocarcinoma. Lung Cancer 2022, 174, 165–171. [Google Scholar] [CrossRef]
- Kagimoto, A.; Tsutani, Y.; Kushitani, K.; Kai, Y.; Kambara, T.; Miyata, Y.; Takeshima, Y.; Okada, M. Segmentectomy vs Lobectomy for Clinical Stage IA Lung Adenocarcinoma With Spread Through Air Spaces. Ann. Thorac. Surg. 2021, 112, 935–943. [Google Scholar] [CrossRef] [PubMed]
- Yoon, H.J.; Kang, J.; Lee, H.Y.; Lee, M.A.; Hwang, N.Y.; Kim, H.K.; Kim, J. Recurrence dynamics after curative surgery in patients with invasive mucinous adenocarcinoma of the lung. Insights Imaging 2022, 13, 64. [Google Scholar] [CrossRef]
- Takahara, T.; Satou, A.; Tsuyuki, T.; Ito, T.; Taniguchi, N.; Yamamoto, Y.; Ohashi, A.; Takahashi, E.; Kadota, K.; Tsuzuki, T. Histology of Bronchiolar Tumor Spread Through Air Spaces. Am. J. Surg. Pathol. 2024, 48, 1052–1059. [Google Scholar] [CrossRef] [PubMed]
- Lee, M.A.; Kang, J.; Lee, H.Y.; Kim, W.; Shon, I.; Hwang, N.Y.; Kim, H.K.; Choi, Y.S.; Kim, J.; Zo, J.I.; et al. Spread through air spaces (STAS) in invasive mucinous adenocarcinoma of the lung: Incidence, prognostic impact, and prediction based on clinicoradiologic factors. Thorac. Cancer 2020, 11, 3145–3154. [Google Scholar] [CrossRef] [PubMed]
- Masai, K.; Sakurai, H.; Sukeda, A.; Suzuki, S.; Asakura, K.; Nakagawa, K.; Asamura, H.; Watanabe, S.-I.; Motoi, N.; Hiraoka, N. Prognostic Impact of Margin Distance and Tumor Spread Through Air Spaces in Limited Resection for Primary Lung Cancer. J. Thorac. Oncol. 2017, 12, 1788–1797. [Google Scholar] [CrossRef] [PubMed]
- Eguchi, T.; Kameda, K.; Lu, S.; Bott, M.J.; Tan, K.S.; Montecalvo, J.; Chang, J.C.; Rekhtman, N.; Jones, D.R.; Travis, W.D.; et al. Lobectomy Is Associated with Better Outcomes than Sublobar Resection in Spread through Air Spaces (STAS)-Positive T1 Lung Adenocarcinoma: A Propensity Score–Matched Analysis. J. Thorac. Oncol. 2019, 14, 87–98. [Google Scholar] [CrossRef] [PubMed]
- Yagi, Y.; Aly, R.G.; Tabata, K.; Barlas, A.; Rekhtman, N.; Eguchi, T.; Montecalvo, J.; Hameed, M.; Manova-Todorova, K.; Adusumilli, P.S.; et al. Three-Dimensional Histologic, Immunohistochemical, and Multiplex Immunofluorescence Analyses of Dynamic Vessel Co-Option of Spread Through Air Spaces in Lung Adenocarcinoma. J. Thorac. Oncol. 2020, 15, 589–600. [Google Scholar] [CrossRef]
- Jung, W.; Chung, J.-H.; Yum, S.; Kim, K.; Lee, C.T.; Jheon, S.; Cho, S. The differential prognostic impact of spread through air spaces in early-stage lung adenocarcinoma after lobectomy according to the pT descriptor. J. Thorac. Cardiovasc. Surg. 2022, 163, 277–284.e1. [Google Scholar] [CrossRef]
- Dai, C.; Xie, H.; Su, H.; She, Y.; Zhu, E.; Fan, Z.; Zhou, F.; Ren, Y.; Xie, D.; Zheng, H.; et al. Tumor Spread through Air Spaces Affects the Recurrence and Overall Survival in Patients with Lung Adenocarcinoma >2 to 3 cm. J. Thorac. Oncol. 2017, 12, 1052–1060. [Google Scholar] [CrossRef]
- Yu, H.; Lin, C.; Chen, X.; Wang, Z.; Shen, W. To explore the prognostic value of spread through air spaces and develop a nomogram combined with spread through air spaces in lung squamous cell carcinoma. J. Thorac. Dis. 2022, 14, 3531–3543. [Google Scholar] [CrossRef]
- Kadota, K.; Kushida, Y.; Katsuki, N.; Ishikawa, R.; Ibuki, E.; Motoyama, M.C.; Nii, K.; Yokomise, H.; Bandoh, S.; Haba, R. Tumor Spread Through Air Spaces Is an Independent Predictor of Recurrence-free Survival in Patients With Resected Lung Squamous Cell Carcinoma. Am. J. Surg. Pathol. 2017, 41, 1077–1086. [Google Scholar] [CrossRef]
- Yanagawa, N.; Shiono, S.; Endo, M.; Ogata, S.-Y. Tumor spread through air spaces is a useful predictor of recurrence and prognosis in stage I lung squamous cell carcinoma, but not in stage II and III. Lung Cancer 2018, 120, 14–21. [Google Scholar] [CrossRef]
- Aly, R.G.; Rekhtman, N.; Li, X.; Takahashi, Y.; Eguchi, T.; Tan, K.S.; Rudin, C.M.; Adusumilli, P.S.; Travis, W.D. Spread Through Air Spaces (STAS) Is Prognostic in Atypical Carcinoid, Large Cell Neuroendocrine Carcinoma, and Small Cell Carcinoma of the Lung. J. Thorac. Oncol. 2019, 14, 1583–1593. [Google Scholar] [CrossRef]
- Altinay, S.; Metovic, J.; Massa, F.; Gatti, G.; Cassoni, P.; Scagliotti, G.V.; Volante, M.; Papotti, M. Spread through air spaces (STAS) is a predictor of poor outcome in atypical carcinoids of the lung. Virchows Arch. 2019, 475, 325–334. [Google Scholar] [CrossRef]
- Wan, S.; Shen, Z.; Hu, S.; Zhang, L.; Yu, H.; Chen, Y.; Wang, J.; Wang, D.; Zhang, J.; Zhang, P. Spread Through Air Spaces in Stage I Pulmonary Large Cell Neuroendocrine Carcinoma. Ann. Thorac. Surg. 2024, 118, 385–393. [Google Scholar] [CrossRef]
- Xie, H.; Dou, S.; Huang, X.; Wen, Y.; Yang, L. The effect of spread through air spaces on postoperative recurrence-free survival in patients with multiple primary lung cancers. World J. Surg. Oncol. 2024, 22, 75. [Google Scholar] [CrossRef]
- Ma, Y.; Zhang, Y.; Li, H.; Li, J.; Chen, H.; Wang, P.; Xiao, R.; Li, X.; Wang, S.; Qiu, M. Spread through air spaces is a common phenomenon of pulmonary metastasized tumours regardless of origins. Eur. J. Cardio-Thoracic Surg. 2021, 61, 1242–1248. [Google Scholar] [CrossRef]
- Takeda-Miyata, N.; Konishi, E.; Tanaka, T.; Shimomura, M.; Tsunezuka, H.; Okada, S.; Ishihara, S.; Ishikawa, N.; Inoue, M. Prognostic significance of spread through air spaces in pulmonary metastases from colorectal cancer. Lung Cancer 2020, 149, 61–67. [Google Scholar] [CrossRef] [PubMed]
- Xie, S.; Liu, Q.; Han, Y.; Wang, S.; Deng, H.; Liu, G. Adjuvant chemotherapy can benefit the survival of stage I lung adenocarcinoma patients with tumour spread through air spaces after resection: Propensity-score matched analysis. Front. Oncol. 2022, 12, 905958. [Google Scholar] [CrossRef] [PubMed]
- Chen, D.; Wang, X.; Zhang, F.; Han, R.; Ding, Q.; Xu, X.; Shu, J.; Ye, F.; Shi, L.; Mao, Y.; et al. Could tumor spread through air spaces benefit from adjuvant chemotherapy in stage I lung adenocarcinoma? A multi-institutional study. Ther. Adv. Med. Oncol. 2020, 12, 1758835920978147. [Google Scholar] [CrossRef] [PubMed]
- Lv, Y.; Li, S.; Liu, Z.; Ren, Z.; Zhao, J.; Tao, G.; Zheng, Z.; Han, Y.; Ye, B. Impact of surgery and adjuvant chemotherapy on the survival of stage I lung adenocarcinoma patients with tumor spread through air spaces. Lung Cancer 2023, 177, 51–58. [Google Scholar] [CrossRef]
- Medina, M.A.; Onken, A.M.; de Margerie-Mellon, C.; Heidinger, B.H.; Chen, Y.; Bankier, A.A.; VanderLaan, P.A. Preoperative bronchial cytology for the assessment of tumor spread through air spaces in lung adenocarcinoma resection specimens. Cancer Cytopathol. 2020, 128, 278–286. [Google Scholar] [CrossRef]
- Makita, K.; Hamamoto, Y.; Kanzaki, H.; Nagasaki, K.; Matsuki, H.; Inoue, K.; Kozuki, T. Association between tumor cell in air space and treatment outcomes in early-stage lung cancer treated with stereotactic body radiation therapy. Clin. Transl. Radiat. Oncol. 2024, 47, 100795. [Google Scholar] [CrossRef]

Disclaimer/Publisher’s Note: The statements, opinions and data contained in all publications are solely those of the individual author(s) and contributor(s) and not of MDPI and/or the editor(s). MDPI and/or the editor(s) disclaim responsibility for any injury to people or property resulting from any ideas, methods, instructions or products referred to in the content. |
© 2025 by the authors. Licensee MDPI, Basel, Switzerland. This article is an open access article distributed under the terms and conditions of the Creative Commons Attribution (CC BY) license (https://creativecommons.org/licenses/by/4.0/).
Share and Cite
Orlandi, R.; Bramati, L.; Andrisani, M.C.; Croci, G.A.; Bareggi, C.; Castiglioni, S.; Romboni, F.; Franzi, S.; Tosi, D. Multidisciplinary Perspective of Spread Through Air Spaces in Lung Cancer: A Narrative Review. Cancers 2025, 17, 3374. https://doi.org/10.3390/cancers17203374
Orlandi R, Bramati L, Andrisani MC, Croci GA, Bareggi C, Castiglioni S, Romboni F, Franzi S, Tosi D. Multidisciplinary Perspective of Spread Through Air Spaces in Lung Cancer: A Narrative Review. Cancers. 2025; 17(20):3374. https://doi.org/10.3390/cancers17203374
Chicago/Turabian StyleOrlandi, Riccardo, Lorenzo Bramati, Maria C. Andrisani, Giorgio A. Croci, Claudia Bareggi, Simona Castiglioni, Francesca Romboni, Sara Franzi, and Davide Tosi. 2025. "Multidisciplinary Perspective of Spread Through Air Spaces in Lung Cancer: A Narrative Review" Cancers 17, no. 20: 3374. https://doi.org/10.3390/cancers17203374
APA StyleOrlandi, R., Bramati, L., Andrisani, M. C., Croci, G. A., Bareggi, C., Castiglioni, S., Romboni, F., Franzi, S., & Tosi, D. (2025). Multidisciplinary Perspective of Spread Through Air Spaces in Lung Cancer: A Narrative Review. Cancers, 17(20), 3374. https://doi.org/10.3390/cancers17203374

